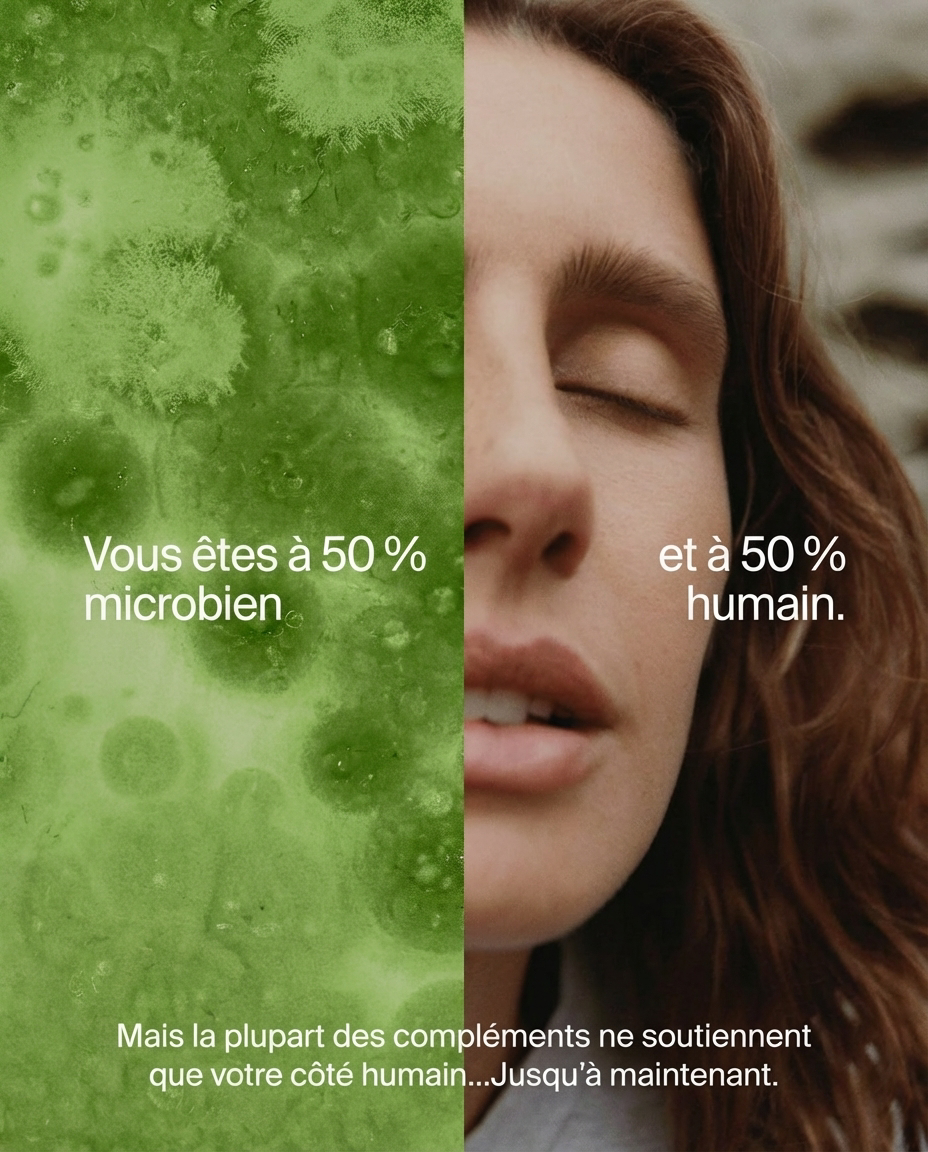

Testé en laboratoire indépendant
Livraison partout au Maroc
Votre intestin contrôle plus que vous ne le croyez.
Énergie. Humeur. Immunité. Peau. Transit.
Tout commence dans votre microbiome.
RACYNE est une formule marocaine développée avec des standards internationaux probiotiques en doses cliniquement efficaces, prébiotiques, et plantes digestives traditionnelles validées par la science moderne.
Parce que prendre soin de l'intérieur change tout ce qui se voit à l'extérieur.

Ce Que Nos Clients Disent
"Enfin quelque chose qui dure vraiment."
"J'avais essayé tellement de choses pour mon ventre — tisanes, médicaments, tout. Rien ne durait. Avec RACYNE j'ai senti la différence après la première semaine. Le ventre gonflé après chaque repas — disparu. Je recommande à toutes mes amies."
"3 semaines et ma vie a changé."
"كنعاني من القولون من زمان et j'avais perdu espoir. Une amie m'a parlé de RACYNE. J'ai commandé sans trop y croire. Maintenant ça fait 3 semaines et la différence est réelle — moins de douleurs, moins de ballonnements. Merci RACYNE."
"Enfin quelque chose qui dure vraiment."
"J'avais essayé tellement de choses pour mon ventre — tisanes, médicaments, tout. Rien ne durait. Avec RACYNE j'ai senti la différence après la première semaine. Le ventre gonflé après chaque repas — disparu. Je recommande à toutes mes amies."
"3 semaines et ma vie a changé."
"كنعاني من القولون من زمان et j'avais perdu espoir. Une amie m'a parlé de RACYNE. J'ai commandé sans trop y croire. Maintenant ça fait 3 semaines et la différence est réelle — moins de douleurs, moins de ballonnements. Merci RACYNE."
"Enfin quelque chose qui dure vraiment."
"J'avais essayé tellement de choses pour mon ventre — tisanes, médicaments, tout. Rien ne durait. Avec RACYNE j'ai senti la différence après la première semaine. Le ventre gonflé après chaque repas — disparu. Je recommande à toutes mes amies."
"3 semaines et ma vie a changé."
"كنعاني من القولون من زمان et j'avais perdu espoir. Une amie m'a parlé de RACYNE. J'ai commandé sans trop y croire. Maintenant ça fait 3 semaines et la différence est réelle — moins de douleurs, moins de ballonnements. Merci RACYNE."
"Enfin quelque chose qui dure vraiment."
"J'avais essayé tellement de choses pour mon ventre — tisanes, médicaments, tout. Rien ne durait. Avec RACYNE j'ai senti la différence après la première semaine. Le ventre gonflé après chaque repas — disparu. Je recommande à toutes mes amies."
"3 semaines et ma vie a changé."
"كنعاني من القولون من زمان et j'avais perdu espoir. Une amie m'a parlé de RACYNE. J'ai commandé sans trop y croire. Maintenant ça fait 3 semaines et la différence est réelle — moins de douleurs, moins de ballonnements. Merci RACYNE."
"Enfin quelque chose qui dure vraiment."
"J'avais essayé tellement de choses pour mon ventre — tisanes, médicaments, tout. Rien ne durait. Avec RACYNE j'ai senti la différence après la première semaine. Le ventre gonflé après chaque repas — disparu. Je recommande à toutes mes amies."
"3 semaines et ma vie a changé."
"كنعاني من القولون من زمان et j'avais perdu espoir. Une amie m'a parlé de RACYNE. J'ai commandé sans trop y croire. Maintenant ça fait 3 semaines et la différence est réelle — moins de douleurs, moins de ballonnements. Merci RACYNE."
"Enfin quelque chose qui dure vraiment."
"J'avais essayé tellement de choses pour mon ventre — tisanes, médicaments, tout. Rien ne durait. Avec RACYNE j'ai senti la différence après la première semaine. Le ventre gonflé après chaque repas — disparu. Je recommande à toutes mes amies."
"3 semaines et ma vie a changé."
"كنعاني من القولون من زمان et j'avais perdu espoir. Une amie m'a parlé de RACYNE. J'ai commandé sans trop y croire. Maintenant ça fait 3 semaines et la différence est réelle — moins de douleurs, moins de ballonnements. Merci RACYNE."


-
 HALAL
HALALToujours halal, par respect pour la nature, la pureté et l'authenticité de chaque formule.
-
 ISO
ISOCertifiés ISO 22000, nous garantissons une qualité sûre et contrôlée à chaque étape de production.
-
 ONSSA
ONSSATous nos compléments alimentaires sont approuvés par l'ONSSA, garantissant leur conformité aux normes marocaines.
Ne ratez rien!
Conseils santé, nouveautés et offres exclusives — directement dans votre boîte mail. Pas de spam. Juste ce qui compte.





